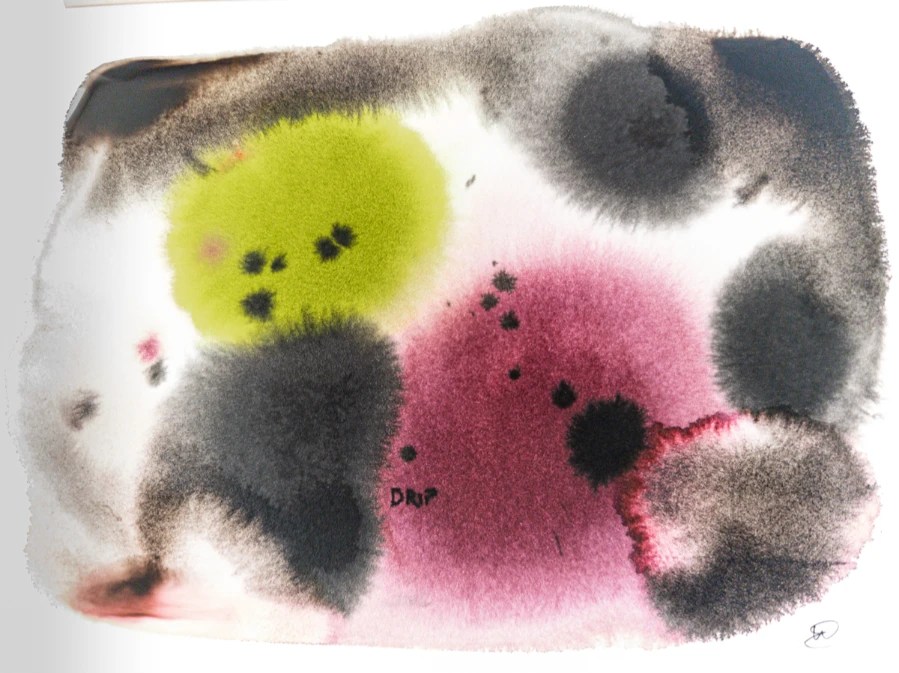

Dies ist nun, was im zweiten Teil des Inktober entstanden ist.
- 7 Drip
- 8 Toad
- 9 Bounce
- 10 Fortune
- 11 Wander
- 12 Spicy






Am 18. Oktober folgen die nächsten sechs Versuche. Bis dahin 🙋🏼♀️
Handarbeit, Inktober, Werkstatt
Dies ist nun, was im zweiten Teil des Inktober entstanden ist.

Am 18. Oktober folgen die nächsten sechs Versuche. Bis dahin 🙋🏼♀️
„Wander“ makes me laugh – it’s wonderful! That awkward, ungainly gait of the toad begins to look quite dignified on your page. I think he’s very serious. „Fortuna“ immediately brings the Middle East to mind…what can we say?
And the last, Spicy drawing has a strange underwater look even though I know these plants are breathing air. Lovely colors, like summer drifting into fall.
LikeGefällt 1 Person
Funny you mention „under water“.That’s what Ben thought, too.
Sketching the toad brought the animal nearer to me, which is often happens with drawing.
LikeGefällt 1 Person
I know what you mean – that’s one of the wonderful things about drawing.
LikeGefällt 1 Person
Ich hatte ganz vergessen, noch mal zurückzukommen. Ich hatte deine ersten Werke schon betrachtet. Das ist ja ein Feuerwerk an Ideen und tollen Umsetzungen bei dir. Das tägliche Zeichnen zahlt sich aus und mir gefallen die verschiedenen Techniken und Ausführungen sehr gut! Tolle Arbeiten 🙂 Man merkt, wieviel Spaß du daran hast.
LikeGefällt 1 Person
Ach, das freut mich sehr. Das Ausprobieren macht wirklich viel Freude, auch wenn manchmal zu einem Stichwort zunächst weit und breit keine Idee in Sicht ist.
LikeGefällt 1 Person
Das merkt man hier aber überhaupt nicht 🙂
LikeGefällt 1 Person
Kommt noch verstärkt beim nächsten Mal.
LikeGefällt 1 Person
Meinst du, das fällt dem Betrachter auf???
LikeGefällt 1 Person
Mal sehen, ob du dann irgendwas auffällig uninspiriert findest.
LikeGefällt 1 Person
Haha. Ich werde mich zu Wort melden. Wir wissen ja beide, daß man selbst es oft anders sieht.
LikeGefällt 1 Person
Sehr abwechslungsreich, ein füllhorn an ideen.😀
LikeGefällt 1 Person
klasse…!……..
LikeGefällt 1 Person
Freut mich, Wolfgang, danke!
LikeLike
Alles sehr ideenreich und ästhetische ansprechend. 🙂
LikeGefällt 1 Person
Freut mich, Joachim, wenn meine Spielereien dich ansprechen. Sie hindern meinen Kopf, den Wahnsinn der Welt allzu nah hereinzulassen.
LikeLike
Alles sehr ideenreich und ästhetische ansprechend. 🙂
LikeLike
Fine post, Ule. Experimenting and playing; a good combi! Have fun.
LikeGefällt 1 Person
Thank you, Harrie. A bit of playing distracts the mind from surrounding horror.
LikeGefällt 1 Person
We’re definitely on the same level here! Take care. ✋
LikeGefällt 1 Person
Wander mochte ich sehr! Sie hat etwas Verschrobenes an sich! Schön!
LikeGefällt 1 Person
Kröten sind wirklich faszinierend und zeichnerisch sehr ergiebig. Dass du gerade diese Zeichnung ansprichst, freut mich sehr, Alexander.
LikeGefällt 1 Person
Ich mag diese Zeichnung sehr. Sie wirkt so draufgängerisch, so eigen, so geheimnisvoll. Ist mir gleich ins Auge gesprungen. Sehr gelungen!!
LikeGefällt 1 Person
Echt beeindruckend 😊
LikeGefällt 1 Person
Das freut mich 🙂
LikeLike
Oh, oh, das Glückshorn schüttet Waffen und Panzer aus, das ist hart. Dafür ist das würzige ganz bezaubernd leicht und ja, … würzig !
LikeGefällt 2 Personen
Leider, Fortunas Füllhorn verteilt fast nur Schrecken über die Welt, täglich mehr, so fühlt es sich an.
Sich auf den Inktober einzulassen schenkt etwas Ablenkung.
LikeGefällt 1 Person
Wahrscheinlich sind auch die griechischen Götter ausgestorben, weil es am Olymp zu heiß wird und im Hades Überschwemmungsgefahr durch den über die Ufer getretenen Styx herrscht. Düstere Grüße
LikeGefällt 1 Person
😎
LikeGefällt 1 Person